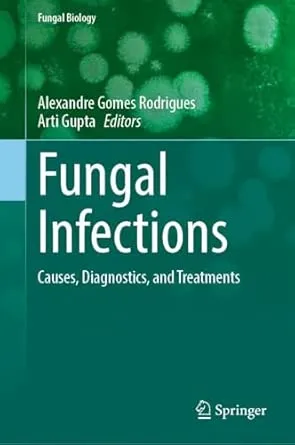

Fungal Infections: Causes, Diagnostics, and Treatments
English | 2025 | ISBN: 3032060133 | 218 Pages | PDF EPUB (True) | 7 MB
English | 2025 | ISBN: 3032060133 | 218 Pages | PDF EPUB (True) | 7 MB
In the last few years research on fungal infections has progressed significantly. Not only have the basic aspects of infections been further investigated but also clinical knowledge has advanced. Also methods to diagnose infections have advanced and robust epidemiological data have been generated, along with new therapeutical approaches created and optimized. To understand and critically evaluate such advances, this new, contemporaneous and dedicated material was founded. It brings together the most relevant data and highlights information in professional, clear, and scientific language to be used by professionals in healthcare systems and researchers in both private and public institutions. Fungal Infections covers recent research and discusses clinically relevant data. This book provides a comprehensive source where the reader can find necessary information from the basic concepts to the clinic and analytical methods. Another important aspect of this workis that it presents current therapies applied to fungal infections and reviews the latest therapeutical innovations, including in the pharmaceutical formulation field. This volume also details recent discoveries from a broad range of subjects from molecular biology to analytics and epidemiology; explains the most recent developments, for example, in terms of diagnostic methods and innovative therapy. It was written by world-class scientists in the field from various countries around the world with the highest quality standards, edited and revised in a peer-review style;. It also includes areas related to infectious diseases like immunocompromised patients, transplants, and immunological aspects, and gives recent data related to Covid-19. This book should be a valuable reference work for students in advanced courses in the medical field as well as for researchers and professionals working in the medical, pharmaceutical, biological, and biotechnological fields.